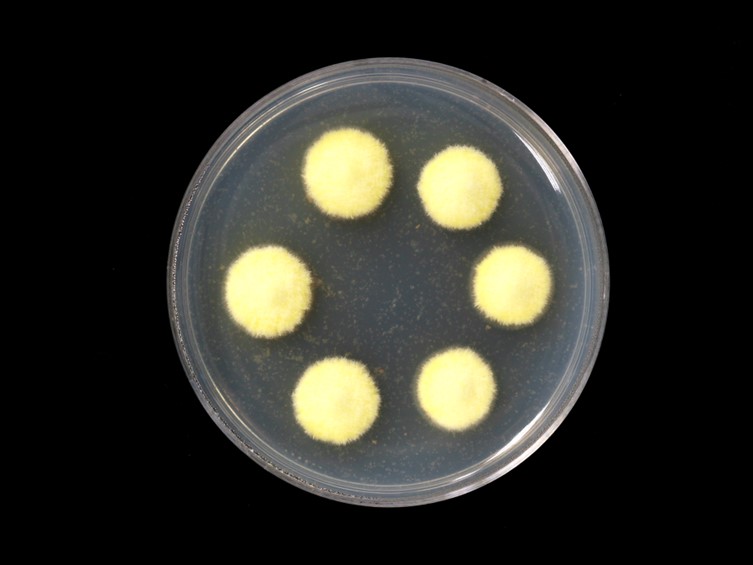

Habitat:
Underside of bamboo leaves.
Host:
Scale insect nymphs (Hemiptera).
Description:
 Stroma covered the host body, ascomata crowded, superficial, ring-like, up to 5 mm diam, yellow mycelium. Perithecia flask-shaped, ca 550-600 μm long, ca 350 μm wide.
Stroma covered the host body, ascomata crowded, superficial, ring-like, up to 5 mm diam, yellow mycelium. Perithecia flask-shaped, ca 550-600 μm long, ca 350 μm wide.  Asci cylindric up to ca 400 μm long, 5-7.5 μm diam with a distinct, thickened hyaline cap, ca 5 μm long, ca 7.5 μm wide.
Asci cylindric up to ca 400 μm long, 5-7.5 μm diam with a distinct, thickened hyaline cap, ca 5 μm long, ca 7.5 μm wide.  Ascospores whole, filiform, ca 350 μm long, 1.5-2 μm.
Ascospores whole, filiform, ca 350 μm long, 1.5-2 μm.
Culture characteristics:
Colonies are moderately fast-growing, attaining a diam of 1 cm after 1 wk, white-yellowish when young, turning cream-yellow with age.
Colonies are moderately fast-growing, attaining a diam of 1 cm after 1 wk, white-yellowish when young, turning cream-yellow with age.
Reference:
Hywel-Jones N L (1997). Torrubiella petchii, a new species of scale insect pathogen from Thailand. Mycological Research 101: 143–145.
DOI: https://doi.org/10.1017/S0953756296002274Johnson D, Sung GH, Hywel-Jones NL, et al. Systematics and evolution of the genus Torrubiella (Hypocreales, Ascomycota). Mycological Research 113: 289–296.
DOI: https://doi.org/10.1016/j.mycres.2008.09.008Species |
Strain |
Compound |
Pubchem CID |
Biological activity |
Reference |
|---|
|
Strain |
LSU | RPB1 | TEF1 |
|---|---|---|---|
| NHJ 6209 | EU369039 | EU369023 | EU369061 |
| NHJ 6240 | EU369038 | U369022 | EU369060 |